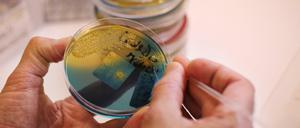
In Gewebeproben eines Hundes suchen Wissenschaftler nach Hinweisen auf den Erreger der Durchfälle. Ein sonst eher harmloses Bakterium könnte die Ursache sein.

Völlig out und doch wieder da: Per Skjelbred ist für Hertha BSC extrem wichtig. Ein Gespräch über Fahrradreifen, das Älterwerden und Pläne nach der Karriere.

Völlig out und doch wieder da: Per Skjelbred ist für Hertha BSC extrem wichtig. Ein Gespräch über Fahrradreifen, das Älterwerden und Pläne nach der Karriere.

Die türkische Invasion in Nordsyrien verstärkt in der EU die Angst vor vielen neuen Flüchtlingen. Wer jetzt kommt, findet eine deutlich andere Lage vor.

Alle reden über Peter Handke, auch in Frankfurt. Aber die Buchmesse hat ein buntes Programm zu bieten, vom Gastland Norwegen bis zum Klimawandel.

Warten auf den Weihnachtsmann: Die Buchmesse in Frankfurt verzichtet aufs übliche Krisengerede.

Dänemark, Finnland, Island, Norwegen und Schweden feiern 20 Jahre Nordische Botschaften in Berlin.

Die Vertretungen der nordischen Länder feiern Jubiläum und zeigen die Ausstellung „Ocean Dwellers“. Die beschäftigt sich mit Veränderungen des Ökosystems.

Fünf Menschen aus fünf Ländern haben sich einst nach Berlin aufgemacht – und möchten gar nicht wieder zurück.

Das Spektakel beginnt: Gastland Norwegen präsentiert sich mit dem Motto „Der Traum in uns“ und Karl Ove Knausgård erinnert an die Kraft der Literatur.

Norwegen ist in diesem Jahr Ehrengast der Frankfurter Buchmesse. Für Comicleser gibt es im Land viel zu entdecken.
Die Polarstern-Expedition unter der Führung des Potsdamer AWI-Forschers Markus Rex hat eine Eisscholle für den Drift durch die Arktis gefunden. Was es aus dem ewigen Eis Neues gibt.

Ein Besuch beim Osloer Autorenpaar Erik Fosnes Hansen und Erika Fatland zeigt, wie sich Norwegens Buchszene wandelt. Auch Jenseits des Trends zur Tristesse.

Zur Eröffnung der Buchmesse werden politische Töne angeschlagen, mit Blick auf den „Terror von rechts“. Nobelpreisträgerin Tokarczuk sorgt sich um Polen.

Karl Ove Knausgård hat eine Ausstellung mit unbekannten Werken von Edvard Munch kuratiert. In seinem neuen Buch sinniert er über den norwegischen Großkünstler.

Naturschutz und ein Kunst-Festival auf den Lofoten – und was Kaiser Wilhelm II. damit zu tun hat.

Der Täter von Halle radikalisierte sich online. Warum die Sicherheitsbehörden das virtuelle Netz der Rechtsterroristen zu wenig im Blick haben. Eine Analyse.

Katrin Glatz-Brubakk von „Ärzte ohne Grenzen“ kennt die Traumata der Jüngsten. Wir trafen die Kinderpsychologin im Camp Moria - und bitten um Spenden.

Mit Diskriminierung musste sich das einzige indigene Volk Europas immer schon auseinandersetzen. Doch auch Klimawandel und Tourismus bleiben nicht folgenlos.

Seit diesem Monat können die Menschen in Norwegen ihren Führerschein als App runterladen. Das soll den Alltag vereinfachen. Datensicherheit ist kein Thema.

Ein Jahr lang soll die „Polarstern“ mit dem Meereis durch die Arktis driften. Die Forscher fanden eine Scholle, an der sich der Eisbrecher festfrieren lässt.

Knut Hamsun war einer der bedeutendsten Schriftsteller Norwegens. Und verehrte Hitler. Das Land fragt sich, wie es dazu kam - und wie es damit umgehen soll.
Unter norwegischen Hunden ist es zu über hundert Fällen von Durchfallerkrankungen mit teils tödlichem Ausgang gekommen. Im Verdacht steht ein Bakterium.

Über Monate eingeschlossen im Eis wollen Forscher herausfinden, wie die Arktis im Winter „tickt“. Die Daten sollen zu besseren Klimamodellen beitragen.

Lebensmittelfirmen aus Berlin können mehr als Pizza und Pralinen. Sie bringen sogar Krebse und Algen auf die Teller.

Mehr als 300 Milliarden Dollar haben chinesische Firmen in Europa investiert. Regiert Peking nun in Brüssel mit? Erstaunliche Ergebnisse einer Recherche.

Der einstige König der Biathleten leitet in China künftig das Projekt Peking 2022. Seine Frau Darja Domratschewa begleitet ihn dabei.

Stress, Stau – und Sonnenuntergang über dem Rastplatz Münsterland. Trucker Florian Kosmowski liebt seinen Job. Doch der Branche droht der Kollaps.

In Norwegen verbreitet sich eine Infektionskrankheit unter Hunden, die mit Durchfall und Erbrechen einhergeht. Viele Tiere sind daran schon gestorben.

Auf der Frankfurter Buchmesse wird es diesen Oktober politisch. Neben dem Buch bekommt das Digitale mehr Raum. Ein Überblick.

200 Millionen Euro stehen zur Verfügung. Jetzt werden die Architekturbüros ausgewählt, die sich am Wettbewerb für die Sanierung beteiligen dürfen.

Hamburg war als Gastgeber nicht immer ein guter Platz für das deutsche Team: 1974 und 1988 gab es historische Niederlagen an der Elbe. Eine kleine Chronik.

Wichtigste Plattform der aktuellen skandinavischen Kunstszene: die Kunstmesse Chart in Kopenhagen.

Brasiliens Regierung bleibt stur. Hinter Hilfsangeboten zum Kampf gegen die Waldbrände vermutet sie böse Absichten. Kanzlerin Merkel telefoniert mit Bolsonaro.

Künstler und Journalisten aus der ganzen Welt reisen extra dafür an: Am Freitag und Samstag findet das Feuerwerkfestival in Berlin statt.

Auch Arktisforscher müssen essen. An Bord des Forschungsschiffs werden sie bekocht von Sven Schnieder. Der hat unter anderem 14.000 Eier eingepackt.

Seit Wochen wüten Waldbrände im Amazonas-Gebiet. Brasiliens Präsident Bolsonaro macht nun Umweltschützer dafür verantwortlich.

American Football ist mehr als ein Hobby, mehr als ein Sport – er ist Schule für das Leben. Unser Autor erklärt, worauf es besonders ankommt.

Ina Abuschenko-Matwejewa und Birgit Cauer präsentieren ihre Norwegen-Eindrücke in der Potsdamer Galerie M.

Sigrid Undset bekam 1928 den Literaturnobelpreis. Sie ist eine der größten Schriftstellerinnen Norwegens. Eine Spurensuche in Lillehammer.

Der Anschlag auf die Moschee in Norwegen wurde rechtzeitig gestoppt. Sicherheitsexperten und Behörden befürchten nun Nachahmungstaten.

Das Bundesumweltministerium kappt wegen der starken Zunahme der Regenwald-Rodung seine Klima-Projekte in Brasilien. Dessen Präsident sagt: Behaltet das Geld.
öffnet in neuem Tab oder Fenster